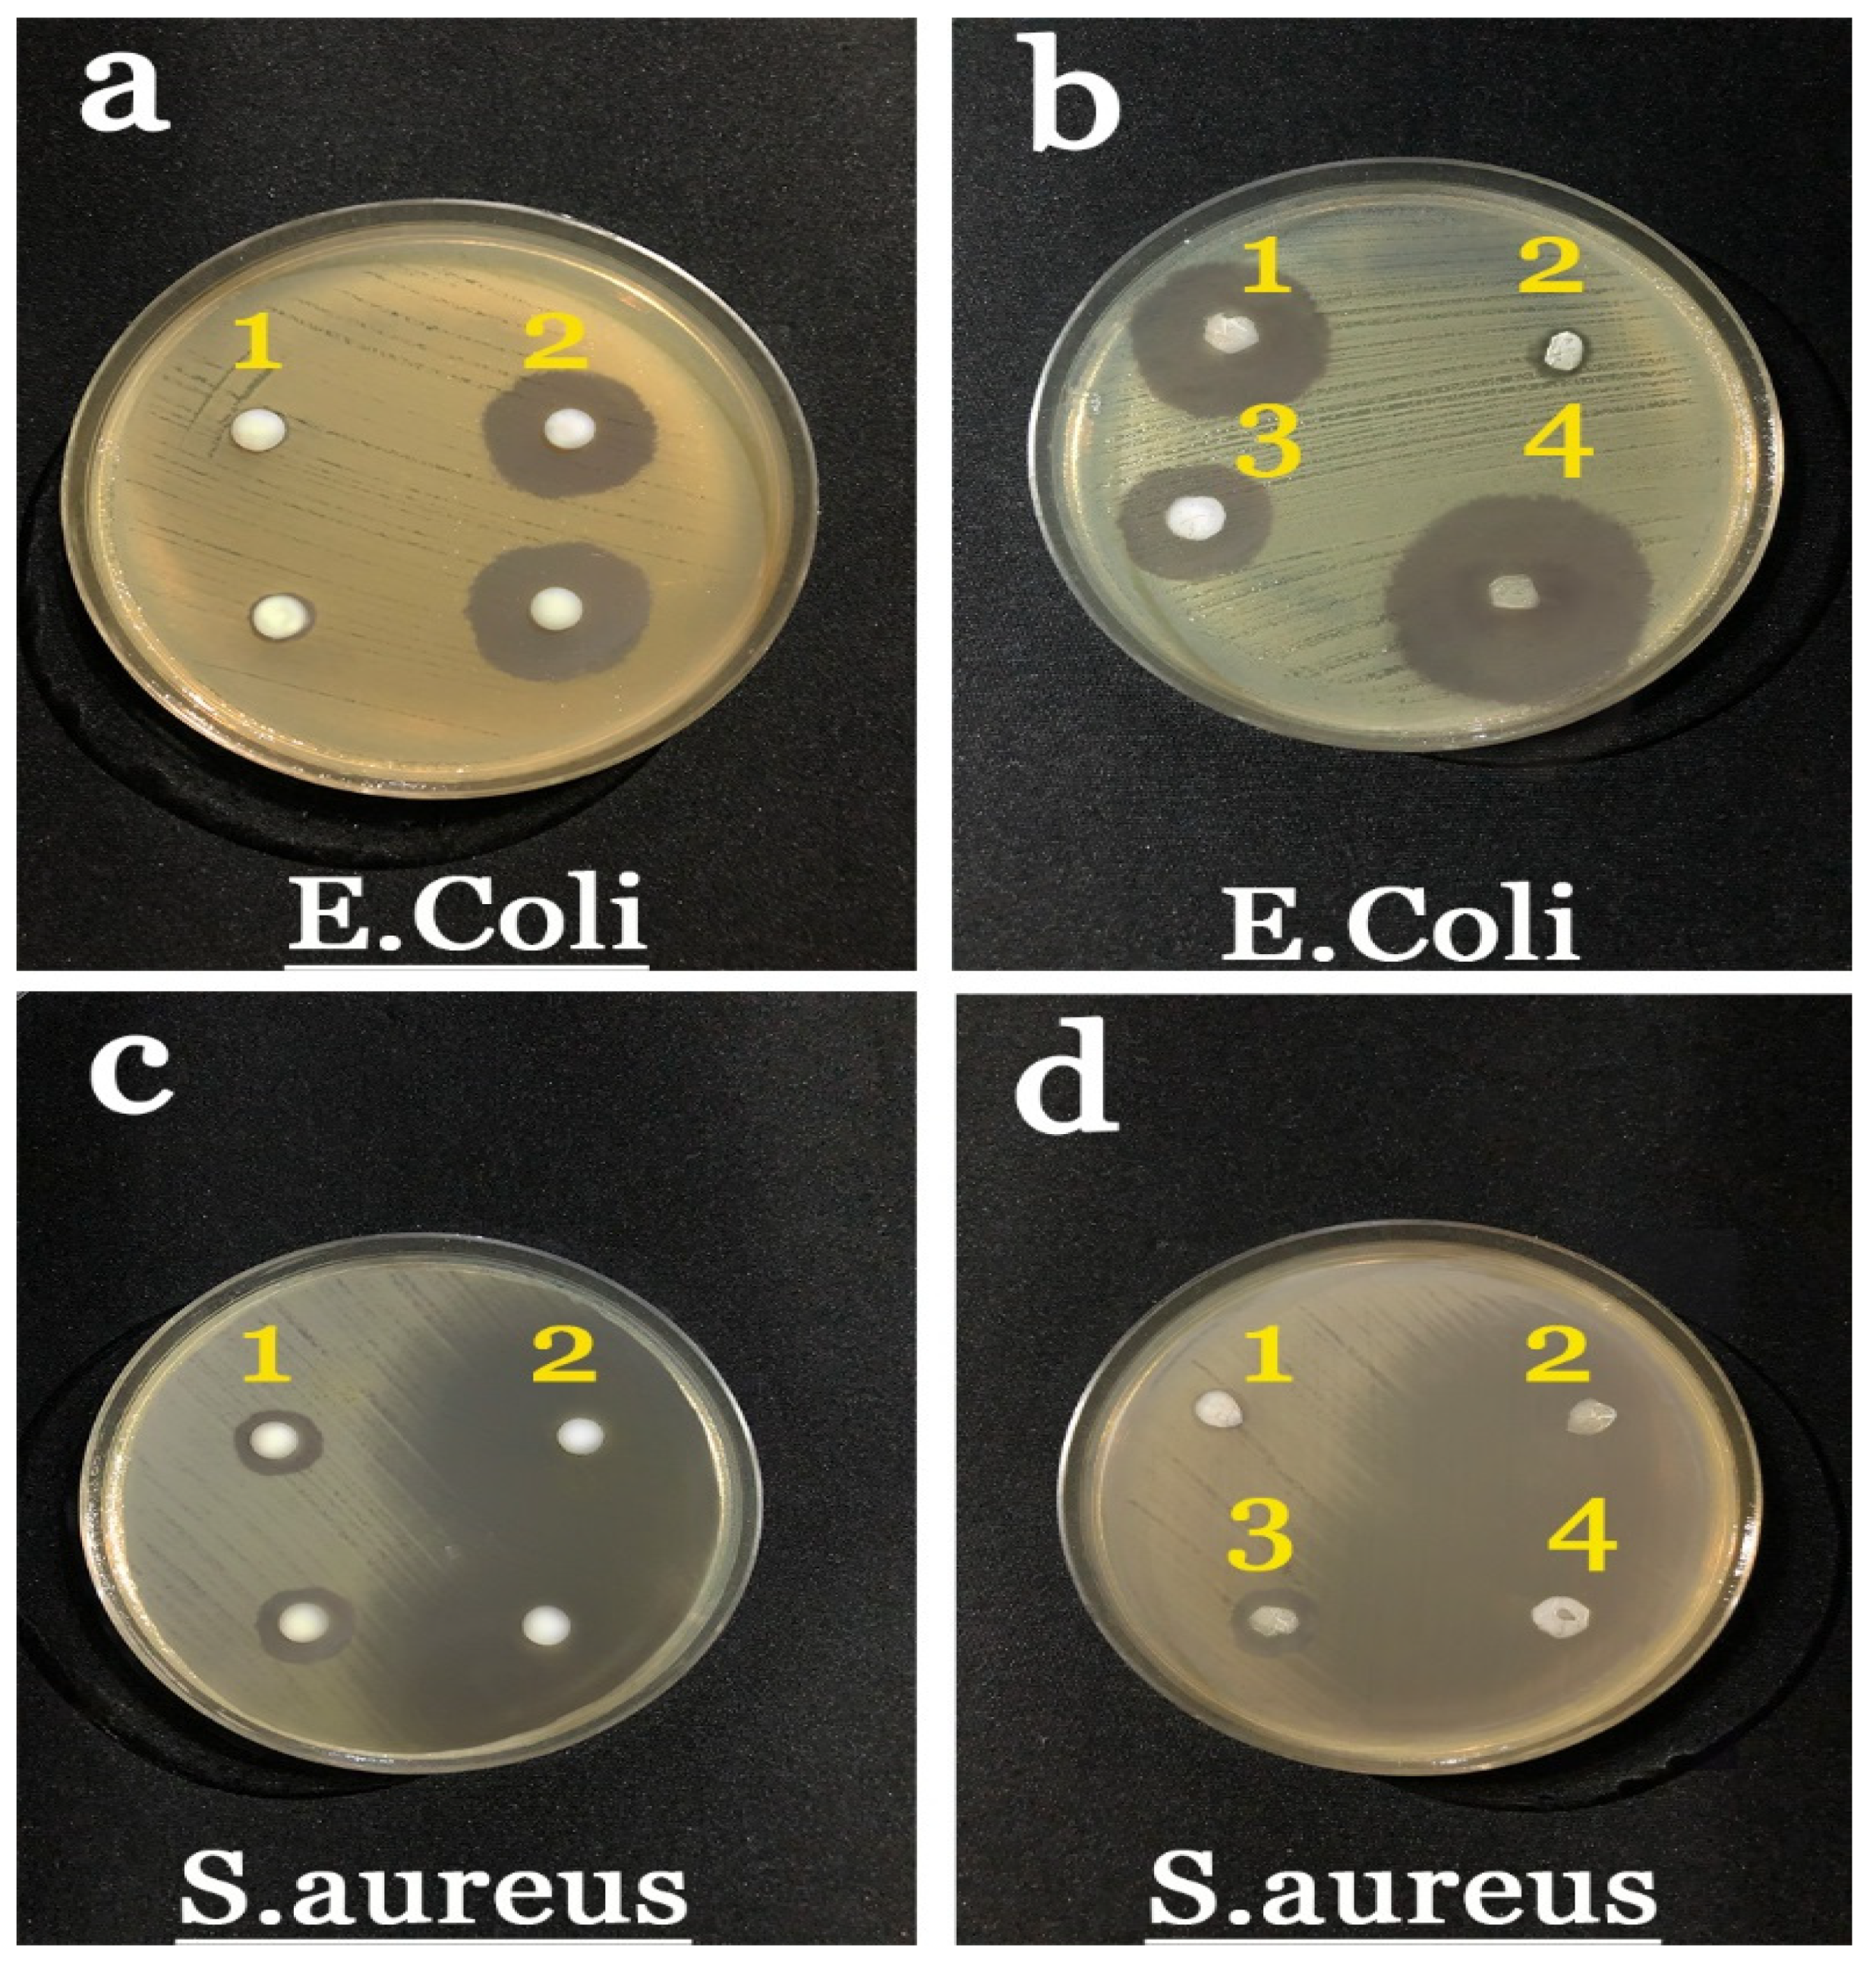
Gels 09 00672 g006

Bromelain- and Silver Nanoparticle-Loaded Polycaprolactone/Chitosan Nanofibrous Dressings for Skin Wound Healing
Abstract
:1. Introduction
2. Results and Discussion
2.1. Characterizations of Ag NPs
2.2. Nanofibrous Scaffold Characterizations
2.3. Fourier Transform Infrared Analysis
2.4. Mechanical Measurement
2.5. Contact Angle of NFs
2.6. BRO Activity
2.7. Antibacterial Results
2.8. MTT Assay Results
2.9. Animal Study
3. Conclusions
4. Materials and Methods
4.1. Materials
4.2. Synthesis of Ag NPs
4.3. Fabrication of Free PCL/CS NFs
4.4. Fabrication of PCL/CS-Ag NPs-BRO Mat
4.5. Washing and Sterilization of Nanofibrous Dressing
4.6. Characterization of Nanofibrous Dressing
4.6.1. Morphology Observation
4.6.2. Fourier Transform Infrared Spectroscopy
4.6.3. Tensile Testing
4.6.4. Contact Angle Determination Test
4.6.5. BRO Activity
4.6.6. Inhibition Zone Assay (Antibacterial Activity Measurements)
4.6.7. Cytotoxicity Test (MTT Assay)
4.6.8. Animal Study
4.7. Statistical Analysis
Author Contributions
Funding
Institutional Review Board Statement
Informed Consent Statement
Data Availability Statement
Conflicts of Interest
References
- Ahmed, J.; Mulla, M.; Arfat, Y.A.; Thai, T.L.A. Mechanical, Thermal, Structural and Barrier Properties of Crab Shell Chitosan/Graphene Oxide Composite Films. Food Hydrocoll. 2017, 71, 141–148. [Google Scholar] [CrossRef]
- Chen, Q.; Xu, A.; Li, Z.; Wang, J.; Zhang, S. Influence of Anionic Structure on the Dissolution of Chitosan in 1-Butyl-3-Methylimidazolium-Based Ionic Liquids. Green Chem. 2011, 13, 3446–3452. [Google Scholar] [CrossRef]
- Bajgai, M.P.; Kim, K.W.; Chandra Parajuli, D.; Yoo, Y.C.; Kim, W.D.; Khil, M.S.; Kim, H.Y. In Vitro Hydrolytic Degradation of Poly(ε-Caprolactone) Grafted Dextran Fibers and Films. Polym. Degrad. Stab. 2008, 93, 2172–2179. [Google Scholar] [CrossRef]
- Loesberg, W.A.; Walboomers, X.F.; Van Loon, J.J.W.A.; Jansen, J.A. The Effect of Combined Hypergravity and Microgrooved Surface Topography on the Behaviour of Fibroblasts. Cell Motil. Cytoskelet. 2006, 63, 384–394. [Google Scholar] [CrossRef] [PubMed]
- Lindahl, U.; Höök, M. Glycosaminoglycans and Their Binding to Biological Macromolecules. Annu. Rev. Biochem. 1978, 47, 385–417. [Google Scholar] [CrossRef]
- Liao, S.; Li, B.; Ma, Z.; Wei, H.; Chan, C.; Ramakrishna, S. Biomimetic Electrospun Nanofibers for Tissue Regeneration. Biomed. Mater. 2006, 1, R45–R53. [Google Scholar] [CrossRef]
- Martínez-Castañón, G.A.; Niño-Martínez, N.; Martínez-Gutierrez, F.; Martínez-Mendoza, J.R.; Ruiz, F. Synthesis and Antibacterial Activity of Silver Nanoparticles with Different Sizes. J. Nanoparticle Res. 2008, 10, 1343–1348. [Google Scholar] [CrossRef]
- Hajji, S.; Khedir, S.B.; Hamza-Mnif, I.; Hamdi, M.; Jedidi, I.; Kallel, R.; Boufi, S.; Nasri, M. Biomedical Potential of Chitosan-Silver Nanoparticles with Special Reference to Antioxidant, Antibacterial, Hemolytic and in Vivo Cutaneous Wound Healing Effects. Biochim. Biophys. Acta Gen. Subj. 2019, 1863, 241–254. [Google Scholar] [CrossRef]
- Gnanadesigan, M.; Anand, M.; Ravikumar, S.; Maruthupandy, M.; Syed Ali, M.; Vijayakumar, V.; Kumaraguru, A.K. Antibacterial Potential of Biosynthesised Silver Nanoparticles Using Avicennia Marina Mangrove Plant. Appl. Nanosci. 2012, 2, 143–147. [Google Scholar] [CrossRef]
- Amoabediny, G.; Salehi-Nik, N.; Heli, B. The Role of Biodegradable Engineered Scaffold in Tissue Engineering. In Biomaterials Science and Engineering; InTech: Rijeka, Croatia, 2011. [Google Scholar]
- Gunn, J.; Zhang, M. Polyblend Nanofibers for Biomedical Applications: Perspectives and Challenges. Trends Biotechnol. 2010, 28, 189–197. [Google Scholar] [CrossRef] [PubMed]
- Arsad, N.K.; Samad, A.A.; Jamaluddin, H. Isolation of Proteolytic Enzyme from Pineapple Crown. Pertanika J. Trop. Agri. Sci. 2023, 46, 607–626. [Google Scholar] [CrossRef]
- Chobotova, K.; Vernallis, A.B.; Majid, F.A.A. Bromelain’s Activity and Potential as an Anti-Cancer Agent: Current Evidence and Perspectives. Cancer Lett. 2010, 290, 148–156. [Google Scholar] [CrossRef]
- Chakraborty, A.J.; Mitra, S.; Tallei, T.E.; Tareq, A.M.; Nainu, F.; Cicia, D.; Dhama, K.; Emran, T.B.; Simal-Gandara, J.; Capasso, R. Bromelain a Potential Bioactive Compound: A Comprehensive Overview from a Pharmacological Perspective. Life 2021, 11, 317. [Google Scholar] [CrossRef]
- Hikisz, P.; Bernasinska-Slomczewska, J. Beneficial Properties of Bromelain. Nutrients 2021, 13, 4313. [Google Scholar] [CrossRef] [PubMed]
- Doostan, M.; Doostan, M.; Mohammadi, P.; Khoshnevisan, K.; Maleki, H. Wound Healing Promotion by Flaxseed Extract-Loaded Polyvinyl Alcohol/Chitosan Nanofibrous Scaffolds. Int. J. Biol. Macromol. 2023, 228, 506–516. [Google Scholar] [CrossRef]
- Khalilimofrad, Z.; Baharifar, H.; Asefnejad, A.; Khoshnevisan, K. Collagen Type I Cross-Linked to Gelatin/Chitosan Electrospun Mats: Application for Skin Tissue Engineering. Mater. Today Commun. 2023, 35, 105889. [Google Scholar] [CrossRef]
- Davarchi, S.M.; Kaffashi, B.; Torabinejad, B.; Zamanian, A. In-Vitro Investigation and Hydrolytic Degradation of Antibacterial Nanocomposites Based on PLLA/Triclosan/Nano-Hydroxyapatite. Polymer 2016, 83, 101–110. [Google Scholar] [CrossRef]
- Maleki, H.; Khoshnevisan, K.; Sajjadi-Jazi, S.M.; Baharifar, H.; Doostan, M.; Khoshnevisan, N.; Sharifi, F. Nanofiber-Based Systems Intended for Diabetes. J. Nanobiotechnol. 2021, 19, 317. [Google Scholar] [CrossRef] [PubMed]
- Kahdim, Q.S.; Abdelmoula, N.; Al-Karagoly, H.; Albukhaty, S.; Al-Saaidi, J. Fabrication of a Polycaprolactone/Chitosan Nanofibrous Scaffold Loaded with Nigella Sativa Extract for Biomedical Applications. BioTech 2023, 12, 19. [Google Scholar] [CrossRef]
- Augustine, R.; Kalarikkal, N.; Thomas, S. Electrospun PCL Membranes Incorporated with Biosynthesized Silver Nanoparticles as Antibacterial Wound Dressings. Appl. Nanosci. 2016, 6, 337–344. [Google Scholar] [CrossRef]
- Madhavan, R.V.; Rosemary, M.J.; Nandkumar, M.A.; Krishnan, K.V.; Krishnan, L.K. Silver Nanoparticle Impregnated Poly (ε-Caprolactone) Scaffolds: Optimization of Antimicrobial and Noncytotoxic Concentrations. Tissue Eng. Part A 2011, 17, 439–449. [Google Scholar] [CrossRef] [PubMed]
- Taylor, P.; Sundaramurthi, D.; Krishnan, U.M. Electrospun Nanofibers as Scaffolds for Skin Tissue Engineering. Polym. Rev. 2014, 54, 348–376. [Google Scholar] [CrossRef]
- Kalwar, K.; Sun, W.X.; Li, D.L.; Zhang, X.J.; Shan, D. Coaxial Electrospinning of Polycaprolactone@chitosan: Characterization and Silver Nanoparticles Incorporation for Antibacterial Activity. React. Funct. Polym. 2016, 107, 87–92. [Google Scholar] [CrossRef]
- Yang, X.; Chen, X.; Wang, H. Acceleration of Osteogenic Differentiation of Preosteoblastic Cells by Chitosan Containing Nanofibrous Scaffolds. Biomacromolecules 2009, 10, 2772–2778. [Google Scholar] [CrossRef]
- Chanda, A.; Adhikari, J.; Ghosh, A.; Chowdhury, S.R.; Thomas, S.; Datta, P.; Saha, P. Electrospun Chitosan/Polycaprolactone-Hyaluronic Acid Bilayered Scaffold for Potential Wound Healing Applications. Int. J. Biol. Macromol. 2018, 116, 774–785. [Google Scholar] [CrossRef]
- Luna-Hernández, E.; Cruz-Soto, M.E.; Padilla-Vaca, F.; Mauricio-Sánchez, R.A.; Ramirez-Wong, D.; Muñoz, R.; Granados-López, L.; Ovalle-Flores, L.R.; Menchaca-Arredondo, J.L.; Hernández-Rangel, A.; et al. Combined Antibacterial/Tissue Regeneration Response in Thermal Burns Promoted by Functional Chitosan/Silver Nanocomposites. Int. J. Biol. Macromol. 2017, 105, 1241–1249. [Google Scholar] [CrossRef]
- Angadi, S.C.; Manjeshwar, L.S.; Aminabhavi, T.M. Stearic Acid-Coated Chitosan-Based Interpenetrating Polymer Network Microspheres: Controlled Release Characteristics. Ind. Eng. Chem. Res. 2011, 50, 4504–4514. [Google Scholar] [CrossRef]
- Maurer, H.R. Bromelain: Biochemistry, Pharmacology and Medical Use. Cell. Mol. Life Sci. 2001, 58, 1234–1245. [Google Scholar] [CrossRef]
- Kim, S.; Choi, J.E.; Choi, J.; Chung, K.H.; Park, K.; Yi, J.; Ryu, D.Y. Oxidative Stress-Dependent Toxicity of Silver Nanoparticles in Human Hepatoma Cells. Toxicol. Vitr. 2009, 23, 1076–1084. [Google Scholar] [CrossRef]
- Ramli, A.N.M.; Manas, N.H.A.; Hamid, A.A.A.; Hamid, H.A.; Illias, R.M. Comparative Structural Analysis of Fruit and Stem Bromelain from Ananas Comosus. Food Chem. 2018, 266, 183–191. [Google Scholar] [CrossRef]
- Bayat, S.; Amiri, N.; Pishavar, E.; Kalalinia, F.; Movaffagh, J.; Hahsemi, M. Bromelain-Loaded Chitosan Nanofibers Prepared by Electrospinning Method for Burn Wound Healing in Animal Models. Life Sci. 2019, 229, 57–66. [Google Scholar] [CrossRef] [PubMed]
- Takahashi, T.; Imai, M.; Suzuki, I.; Sawai, J. Growth Inhibitory Effect on Bacteria of Chitosan Membranes Regulated with Deacetylation Degree. Biochem. Eng. J. 2008, 40, 485–491. [Google Scholar] [CrossRef]
- Li, J.H.; Shao, X.S.; Zhou, Q.; Li, M.Z.; Zhang, Q.Q. The Double Effects of Silver Nanoparticles on the PVDF Membrane: Surface Hydrophilicity and Antifouling Performance. Appl. Surf. Sci. 2013, 265, 663–670. [Google Scholar] [CrossRef]
- No, H.K.; Young Park, N.; Ho Lee, S.; Meyers, S.P. Antibacterial Activity of Chitosans and Chitosan Oligomers with Different Molecular Weights. Int. J. Food Microbiol. 2002, 74, 65–72. [Google Scholar] [CrossRef]
- Thompson, E.A.; Graham, E.; Macneill, C.M.; Young, M.; Donati, G.; Wailes, E.M.; Jones, B.T.; Levi-Polyachenko, N.H. Differential Response of MCF7, MDA-MB-231, and MCF 10A Cells to Hyperthermia, Silver Nanoparticles and Silver Nanoparticle-Induced Photothermal Therapy. Int. J. Hyperth. 2014, 30, 312–323. [Google Scholar] [CrossRef]
- Li, X.; Xie, J.; Liao, L.; Jiang, X.; Fu, H. UV-Curable Polyurethane Acrylate–Ag/TiO2 Nanocomposites with Superior UV Light Antibacterial Activity. Int. J. Polym. Mater. Polym. Biomater. 2017, 66, 835–843. [Google Scholar] [CrossRef]
- Song, K.C.; Lee, S.M.; Park, T.S.; Lee, B.S. Preparation of Colloidal Silver Nanoparticles by Chemical Reduction Method. Korean J. Chem. Eng. 2009, 26, 153–155. [Google Scholar] [CrossRef]
- Liu, X.; Lee, P.Y.; Ho, C.M.; Lui, V.C.H.; Chen, Y.; Che, C.M.; Tam, P.K.H.; Wong, K.K.Y. Silver Nanoparticles Mediate Differential Responses in Keratinocytes and Fibroblasts during Skin Wound Healing. ChemMedChem 2010, 5, 468–475. [Google Scholar] [CrossRef]
- Chinnasamy, G.; Chandrasekharan, S.; Koh, T.W.; Bhatnagar, S. Synthesis, characterization, antibacterial and wound healing efficacy of silver nanoparticles from Azadirachta indica. Front. Microbiol. 2021, 12, 611560. [Google Scholar] [CrossRef]
- Vijayakumar, V.; Samal, S.K.; Mohanty, S.; Nayak, S.K. Recent advancements in biopolymer and metal nanoparticle-based materials in diabetic wound healing management. Int. J. Biol. Macromol. 2019, 122, 137–148. [Google Scholar] [CrossRef]
- Soheilifar, S.; Bidgoli, M.; Hooshyarfard, A.; Shahbazi, A.; Vahdatinia, F.; Khoshkhooie, F. Effect of oral bromelain on wound healing, pain, and bleeding at donor site following free gingival grafting: A clinical trial. J. Dent. 2018, 15, 309. [Google Scholar]
- Cai, E.Z.; Ang, C.H.; Raju, A.; Tan, K.B.; Hing, E.C.; Loo, Y.; Wong, Y.C.; Lee, H.; Lim, J.; Moochhala, S.M.; et al. Creation of consistent burn wounds: A rat model. Arch. Plast. Surg. 2014, 41, 317–324. [Google Scholar] [CrossRef]
- Yao, C.H.; Lee, C.Y.; Huang, C.H.; Chen, Y.S.; Chen, K.Y. Novel Bilayer Wound Dressing Based on Electrospun Gelatin/Keratin Nanofibrous Mats for Skin Wound Repair. Mater. Sci. Eng. C 2017, 79, 533–540. [Google Scholar] [CrossRef] [PubMed]
- Zhang, X.; Jia, C.; Qiao, X.; Liu, T.; Sun, K. Porous Poly(Glycerol Sebacate) (PGS) Elastomer Scaffolds for Skin Tissue Engineering. Polym. Test. 2016, 54, 118–125. [Google Scholar] [CrossRef]
- Nadim, A.; Khorasani, S.N.; Kharaziha, M.; Davoodi, S.M. Design and Characterization of Dexamethasone-Loaded Poly (Glycerol Sebacate)-Poly Caprolactone/Gelatin Scaffold by Coaxial Electro Spinning for Soft Tissue Engineering. Mater. Sci. Eng. C 2017, 78, 47–58. [Google Scholar] [CrossRef] [PubMed]
- Shah, S.A.; Sohail, M.; Khan, S.; Minhas, M.U.; de Matas, M.; Sikstone, V.; Hussain, Z.; Abbasi, M.; Kousar, M. Biopolymer-Based Biomaterials for Accelerated Diabetic Wound Healing: A Critical Review. Int. J. Biol. Macromol. 2019, 139, 975–993. [Google Scholar] [CrossRef] [PubMed]
- Michailidou, G.; Christodoulou, E.; Nanaki, S.; Barmpalexis, P.; Karavas, E.; Vergkizi-Nikolakaki, S.; Bikiaris, D.N. Super-Hydrophilic and High Strength Polymeric Foam Dressings of Modified Chitosan Blends for Topical Wound Delivery of Chloramphenicol. Carbohydr. Polym. 2019, 208, 1–13. [Google Scholar] [CrossRef] [PubMed]
- Vig, K.; Chaudhari, A.; Tripathi, S.; Dixit, S.; Sahu, R.; Pillai, S.; Dennis, V.A.; Singh, S.R. Advances in Skin Regeneration Using Tissue Engineering. Int. J. Mol. Sci. 2017, 18, 789. [Google Scholar] [CrossRef]
- Najafabadi, S.A.A.; Mohammadi, A.; Kharazi, A.Z. Polyurethane Nanocomposite Impregnated with Chitosan-Modified Graphene Oxide as a Potential Antibacterial Wound Dressing. Mater. Sci. Eng. C 2020, 115, 110899. [Google Scholar] [CrossRef]
- Kausar, R.; Khan, A.; Jamil, B.; Shahzad, Y.; ul-Haq, I. Development and Pharmacological Evaluation of Vancomycin Loaded Chitosan Films. Carbohydr. Polym. 2021, 256, 117565. [Google Scholar] [CrossRef]
- Dart, A.; Bhave, M.; Kingshott, P. Antimicrobial Peptide-Based Electrospun Fibers for Wound Healing Applications. Macromol. Biosci. 2019, 19, e1800488. [Google Scholar] [CrossRef]
- Lumbreras-Aguayo, A.; Meléndez-Ortiz, H.I.; Puente-Urbina, B.; Alvarado-Canché, C.; Ledezma, A.; Romero-García, J.; Betancourt-Galindo, R. Poly(Methacrylic Acid)-Modified Medical Cotton Gauzes with Antimicrobial and Drug Delivery Properties for Their Use as Wound Dressings. Carbohydr. Polym. 2019, 205, 203–210. [Google Scholar] [CrossRef]
- Fan, Z.; Liu, B.; Wang, J.; Zhang, S.; Lin, Q.; Gong, P.; Ma, L.; Yang, S. A Novel Wound Dressing Based on Ag/Graphene Polymer Hydrogel: Effectively Kill Bacteria and Accelerate Wound Healing. Adv. Funct. Mater. 2014, 24, 3933–3943. [Google Scholar] [CrossRef]
- Li, L.; Hsieh, Y. Lo Chitosan Bicomponent Nanofibers and Nanoporous Fibers. Carbohydr. Res. 2006, 341, 374–381. [Google Scholar] [CrossRef]
- Sahoo, S.; Sasmal, A.; Nanda, R.; Phani, A.R.; Nayak, P.L. Synthesis of Chitosan-Polycaprolactone Blend for Control Delivery of Ofloxacin Drug. Carbohydr. Polym. 2010, 79, 106–113. [Google Scholar] [CrossRef]
- Malheiro, V.N.; Caridade, S.G.; Alves, N.M.; Mano, J.F. New Poly(ε-Caprolactone)/Chitosan Blend Fibers for Tissue Engineering Applications. Acta Biomater. 2010, 6, 418–428. [Google Scholar] [CrossRef]
- Neves, S.C.; Moreira Teixeira, L.S.; Moroni, L.; Reis, R.L.; Van Blitterswijk, C.A.; Alves, N.M.; Karperien, M.; Mano, J.F. Chitosan/Poly(ε-Caprolactone) Blend Scaffolds for Cartilage Repair. Biomaterials 2011, 32, 1068–1079. [Google Scholar] [CrossRef]
- Gholipour-Kanani, A.; Bahrami, S.H.; Joghataie, M.T.; Samadikuchaksaraei, A. Nanofibrous Scaffolds Based on Poly (Caprolactone)/Chitosan/Poly (Vinyl Alcohol) Blend for Skin Tissue Engineering. Iran. J. Polym. Sci. Technol. 2013, 26, 159–170. [Google Scholar]
- Eskandarinia, A.; Kefayat, A.; Agheb, M.; Rafienia, M.; Amini Baghbadorani, M.; Navid, S.; Ebrahimpour, K.; Khodabakhshi, D.; Ghahremani, F. A Novel Bilayer Wound Dressing Composed of a Dense Polyurethane/Propolis Membrane and a Biodegradable Polycaprolactone/Gelatin Nanofibrous Scaffold. Sci. Rep. 2020, 10, 3063. [Google Scholar] [CrossRef] [PubMed]
- Franco, R.A.; Min, Y.K.; Yang, H.M.; Lee, B.T. Fabrication and Biocompatibility of Novel Bilayer Scaffold for Skin Tissue Engineering Applications. J. Biomater. Appl. 2013, 27, 605–615. [Google Scholar] [CrossRef]
- Hinrichs, W.L.; Lommen, E.J.; Wildevuur, C.R.; Feijen, J. Fabrication and Characterization of an Asymmetric Polyurethane Membrane for Use as a Wound Dressing. J. Appl. Biomater. 1992, 3, 287–303. [Google Scholar] [CrossRef]
- Zhang, L.; Webster, T.J. Nanotechnology and Nanomaterials: Promises for Improved Tissue Regeneration. Nano Today 2009, 4, 66–80. [Google Scholar] [CrossRef]
- Tsao, C.T.; Chang, C.H.; Lin, Y.Y.; Wu, M.F.; Wang, J.L.; Han, J.L.; Hsieh, K.H. Antibacterial Activity and Biocompatibility of a Chitosan-γ- Poly(Glutamic Acid) Polyelectrolyte Complex Hydrogel. Carbohydr. Res. 2010, 345, 1774–1780. [Google Scholar] [CrossRef] [PubMed]
- Tamara, F.R.; Lin, C.; Mi, F.L.; Ho, Y.C. Antibacterial Effects of Chitosan/Cationic Peptide Nanoparticles. Nanomaterials 2018, 8, 88. [Google Scholar] [CrossRef] [PubMed]
- Wang, Y.; Wang, C.; Xie, Y.; Yang, Y.; Zheng, Y.; Meng, H.; He, W.; Qiao, K. Highly Transparent, Highly Flexible Composite Membrane with Multiple Antimicrobial Effects Used for Promoting Wound Healing. Carbohydr. Polym. 2019, 222, 114985. [Google Scholar] [CrossRef] [PubMed]
- López-Iglesias, C.; Barros, J.; Ardao, I.; Monteiro, F.J.; Alvarez-Lorenzo, C.; Gómez-Amoza, J.L.; García-González, C.A. Vancomycin-Loaded Chitosan Aerogel Particles for Chronic Wound Applications. Carbohydr. Polym. 2019, 204, 223–231. [Google Scholar] [CrossRef]

| PCL/CS Ratio | Average Size ± (SD) nm | Bead Formation | Spinnability of the Solution |
|---|---|---|---|
| 50:50 | 212 ± 25 | High | Unsuccessful |
| 60:40 | 123 ± 24 | Rare | Successful |
| 70:30 | 104 ± 21 | Rare | Unsuccessful |
| Samples | N.C | a | b | c | d | P.C |
|---|---|---|---|---|---|---|
| Toxicity % | 0.10 ± 0.02 | 40.49 ± 3.21 | 12.89 ± 1.57 | 18.79 ±1.23 | 10.44 ± 1.17 | 88.98 ± 5.27 |
Disclaimer/Publisher’s Note: The statements, opinions and data contained in all publications are solely those of the individual author(s) and contributor(s) and not of MDPI and/or the editor(s). MDPI and/or the editor(s) disclaim responsibility for any injury to people or property resulting from any ideas, methods, instructions or products referred to in the content. |
© 2023 by the authors. Licensee MDPI, Basel, Switzerland. This article is an open access article distributed under the terms and conditions of the Creative Commons Attribution (CC BY) license (https://creativecommons.org/licenses/by/4.0/).
Share and Cite
Saghafi, Y.; Baharifar, H.; Najmoddin, N.; Asefnejad, A.; Maleki, H.; Sajjadi-Jazi, S.M.; Bonkdar, A.; Shams, F.; Khoshnevisan, K. Bromelain- and Silver Nanoparticle-Loaded Polycaprolactone/Chitosan Nanofibrous Dressings for Skin Wound Healing. Gels 2023, 9, 672. https://doi.org/10.3390/gels9080672
Saghafi Y, Baharifar H, Najmoddin N, Asefnejad A, Maleki H, Sajjadi-Jazi SM, Bonkdar A, Shams F, Khoshnevisan K. Bromelain- and Silver Nanoparticle-Loaded Polycaprolactone/Chitosan Nanofibrous Dressings for Skin Wound Healing. Gels. 2023; 9(8):672. https://doi.org/10.3390/gels9080672
Chicago/Turabian StyleSaghafi, Yasaman, Hadi Baharifar, Najmeh Najmoddin, Azadeh Asefnejad, Hassan Maleki, Sayed Mahmoud Sajjadi-Jazi, Alireza Bonkdar, Forough Shams, and Kamyar Khoshnevisan. 2023. "Bromelain- and Silver Nanoparticle-Loaded Polycaprolactone/Chitosan Nanofibrous Dressings for Skin Wound Healing" Gels 9, no. 8: 672. https://doi.org/10.3390/gels9080672
APA StyleSaghafi, Y., Baharifar, H., Najmoddin, N., Asefnejad, A., Maleki, H., Sajjadi-Jazi, S. M., Bonkdar, A., Shams, F., & Khoshnevisan, K. (2023). Bromelain- and Silver Nanoparticle-Loaded Polycaprolactone/Chitosan Nanofibrous Dressings for Skin Wound Healing. Gels, 9(8), 672. https://doi.org/10.3390/gels9080672

